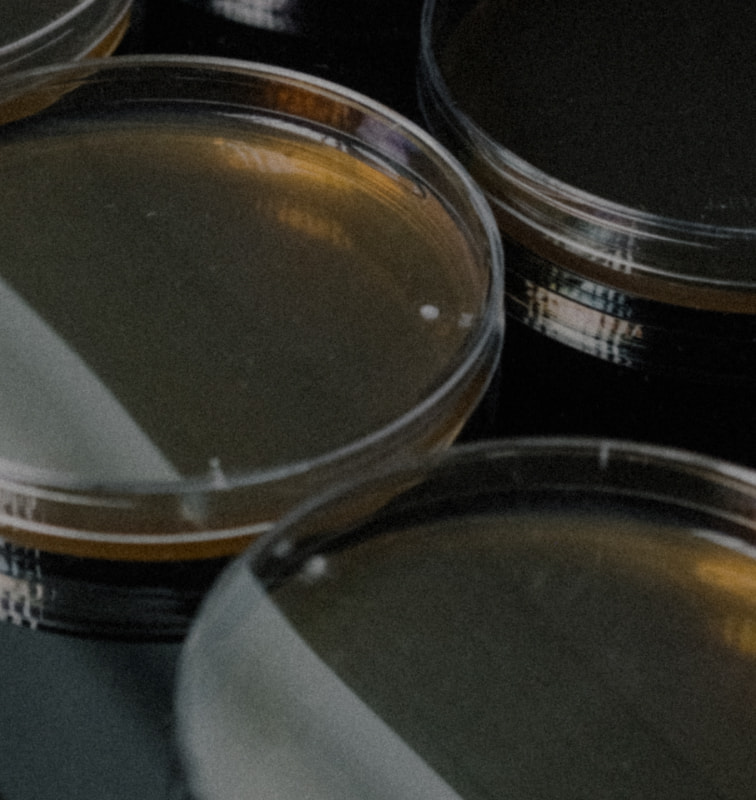

From plate design to organism insights. All in one place.
Design plates fast and consistently without spreadsheets or handwritten notes. Plate Designer helps you define plate layouts faster with clear, structured metadata that flows directly into downstream analysis.
Experiment reproducibility starts with high quality data

Built on millions of images
No need to train your own models – ours are already trained on more than 40 million images for out-of-the-box accuracy.

Your digital notebook
Don’t risk losing physical records, Post-its or unintelligible notes. Reshape automatically records and stores all your data.

Uniform data, every time
Standardize data capture across teams, labs, and time zones, so it’s done the same way, every time, by anyone.

Complete audit trail
Every change is tracked, giving you a full, searchable history to meet compliance standards with confidence.






Fast plate mapping at scale
Instead of defining wells one by one, Plate Designer lets you work with plates the way you think about them: in groups, patterns, or sections.
Organisms

Media

Treatments

Plate designs you can take to the bench
Turn plate designs into clear, visual layouts that mirror the physical plate—helping researchers quickly understand what goes into each well when preparing plates in the lab.
Try it out
Turn plate properties into actionable insight
In the Library, well and plate properties are brought together with analysis results. This makes it easy to compare conditions, understand variation, and learn which combinations drive the best outcomes, so assays can easily be refined and optimized.


“With the help of Reshape, we have moved further in improving the workflow in 6 months than in the 3 years before with other solutions we tried.”
After harvest, the time invested in scoring germination ability was very high (4 people for 3 days). Now it’s basically just me operating the Smart Incubator, and the AI model giving me the data. Everyone else can stay on their projects.
"The Reshape system has revolutionized how we screen and study microbial clones. We can now track metabolite production, release, and diffusion at an unprecedented scale.”
Already using Reshape?


